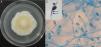

Mycotic ocular infections caused by the Scedosporium apiospermum species complex are challenging to treat because of the delayed diagnoses and poor responses to antifungal drugs and surgical treatment.
Case reportA case of a 69-year-old male patient with a history of diabetes mellitus type 2 and prior surgery on the right femur is described. In the 10 days prior to the ophthalmic consultation he started with ocular pain, adding to a previous and progressive loss of visual acuity in his right eye. The diagnosis of endophthalmitis of probable endogenous origin was established. Despite medical treatment, the patient's condition worsened and, due to the imminent risks, an enucleation was performed. Smears of the enucleation tissue revealed fungal cells, and the cultures yielded a fungus belonging to the S. apiospermum species complex, which was identified as Scedosporium boydii by morphological characteristics and sequencing of a PCR amplicon.
ConclusionsA diagnosis of endophthalmitis of probable endogenous origin in the right eye was based on a previous right femur surgery. Potential risk to the patient led to enucleation.
Las infecciones micóticas oculares causadas por el complejo de especies de Scedosporium apiospermum son un reto en el tratamiento por su diagnóstico tardío y la pobre respuesta a los antimicóticos y al tratamiento quirúrgico.
Caso clínicoSe describe el caso de un paciente de sexo masculino de 69 años con antecedentes de diabetes mellitus de tipo 2 y cirugía previa del fémur derecho. Diez días antes de la consulta oftalmológica comenzó con dolor ocular que se sumaba a una pérdida previa y progresiva de la capacidad visual en el ojo derecho. Se estableció el diagnóstico de endoftalmitis de posible origen endógeno. A pesar del tratamiento, el paciente no presentó mejoría y por los inminentes riesgos se decidió llevar a cabo una enucleación. El frotis a partir del tejido enucleado mostró células fúngicas y los cultivos revelaron un hongo perteneciente al complejo S. apiospermum, identificado como Scedosporium boydii por procedimientos morfológicos y por secuenciación de un amplicón de PCR.
ConclusionesEl diagnóstico de endoftalmitis de probable origen endógeno en el ojo derecho se basó en el antecedente de una cirugía previa de fémur, cuyos riesgos para el paciente condujeron a una enucleación.
The few ocular infection cases shown to be caused by the Scedosporium apiospermum species complex have been a challenge to treat because of the delayed diagnoses, and poor response to antifungal drugs and surgical treatment.1
Patients diagnosed with fungal endogenous endophthalmitis are associated with transient fungaemia and/or underlying systemic disorders. Patients with uncontrolled diabetes mellitus, long periods of antibiotic treatment, or immunosuppression therapy are at risk for endogenous endophthalmitis.2 Conversely, there are some reports stating that corneal infection with the Scedosporium species complex is associated with traumatic injuries and concomitant exogenous endophthalmitis.15
Some upper respiratory tract fungal infections have been associated with exogenous fungal endophthalmitis due to the loss of the natural mechanical barriers by destruction of the periorbital paranasal sinus bone walls. Candida species have been reported as a frequent cause of endogenous endophthalmitis via the haematogenous route in drug abusers, in patients under prolonged broad spectrum antibiotic therapy, or in patients after intestinal septic embolism.16,18Aspergillus spp., Fusarium spp. and some pigmented fungi have also been associated with this pathology, and these fungi commonly induce a poor visual outcome.9,12 Endophthalmitis cases with both traumatic and non-traumatic origin have been described, indicating a severe septicaemia condition.7 Here we report an endogenous fungal endophthalmitis case in a diabetic patient with a previous femur surgery, delayed diagnosis and a poor therapy outcome.
Case reportA 69-year-old man diagnosed 6 years before with diabetes mellitus (not well controlled with glibenclamide due to the irregular intake of the medication), and with chronic arterial hypertension (treated irregularly with captopril) underwent surgery of the right femur 9 months before his first ophthalmic visit. He sought ocular medical assistance due to several symptoms: right ocular pain for the last 10 days, progressive loss of vision over the past 8 months and the presence of a central white spot on his right eye cornea for the last 4 days.
The ocular examination showed that the right eye pupil was unresponsive to direct or consensual papillary reflex. Corneal edema, 100% hypopyon, hyperemic conjunctiva, and ciliar reaction of the limbus were present. The intraocular pressure (IOP) was 2mmHg, and the patient indicated no light perception. No other disorders were visible.
Since our first ocular evaluation, we found that the vision and direct papillary reflex of the left eye were normal, and the anterior segment had no signs of inflammation. The IOP was 10mmHg, cup 0.65, and there were no signs of diabetic retinopathy. The patient was receiving treatment with timolol, brimonidine, dorzolamide, and latanoprost for open angle glaucoma in the left eye.
The patient was hospitalized with a clinical diagnosis of endophthalmitis in the blind and painful right eye. An ultrasound showed total funnel retinal detachment in contact with the posterior lens capsule (Fig. 1); there were no mobile condensations in the vitreous cavity or diffuse inflammatory thickening of the choroid. The haematogenous abnormalities were leukocyte cell count 9000mm–3; 48.9mg/dl glucose; 53.6mg/dl blood urea; 1.47mg/dl blood creatinin.
All anti-glaucoma drugs for the left eye were discontinued as the patient did not have an optic disk glaucoma lesion. For the right eye, enucleation was successfully performed, and the post-operative course was satisfactory.
The extracted tissue was sent for microbiological and histopathology studies. A Gram stain showed that no bacteria were present. The periodic acid Schiff (Fig. 2) and Grocott stains revealed thin septate hyphae, which were surrounded by histiocytes, neutrophils, and necrotic debris. The hyphae were located throughout the retina and choroid. Fibrosis and retinal atrophic changes (gliosis and loss of ganglion cells) were observed around the main lesion. The cornea presented with ulceration and polymorphonuclear leukocyte infiltration, but fungal cells were not observed in the corneal structures.
The blood agar and chocolate agar cultures were incubated in a 5% CO2 anaerobic atmosphere at 37°C. The culture on Sabouraud–Emmons agar was aerobically incubated at 27°C. Fungal growth was observed in all cultures after 5–8 days. On blood agar, several tan, cottony/powdered fungal colonies developed (Fig. 3). On chocolate agar, gray, white cottony colonies were observed. On Sabouraud–Emmons agar, white cottony colonies, which turned to dark brown after 30 days, developed. No aerobic or anaerobic bacteria grew after 15 days of incubation at 37°C.
In order to study the macroscopic and microscopic morphology, a new culture and microculture from a monosporic subculture were performed on potato dextrose agar. For the PCR study, DNA from a monosporic culture in Sabouraud dextrose broth was extracted using a commercial kit (Exgene Plant SV, GeneAll®, Korea) following the manufacturer's instructions. For the PCR, the ITS1-ITS4 oligonucleotides were used as recommended by Luo and Mitchell.13 The PCR components for each reaction were: 100ng of DNA, 2mM MgCl, 0.25mM dNTPs, 0.2μM oligonucleotides, and 3.5U Taq (Thermo Scientific, USA). An approximately 600bp fragment was obtained and then sequenced using the Big Dye Terminator version 3.1 Sequencing kit14 on an ABI 3130xl Genetic Analyzer (Applied Biosystem HITACHI).
On potato dextrose agar, the rapidly growing colony consisted of a fluffy aerial mycelium, which was at first white but then became cinnamon-brown (Fig. 4A). Microscopic examination showed hyaline hyphae (1–2μm in diameter), pyriform annelloconidia (4μm×6μm) borned singly on branched or simple elongate conidiophores (Fig. 4B and C). These characteristics were not significantly different among the three culture media used. After three weeks, brown to black round shaped-cleistothecia (140–200μm) with ellipsoidal, smooth-walled, pale yellow to golden brown ascospores (7μm×4.5μm), were observed (Fig. 5A and B). Tufts of conidiophores forming elongated synnemata of the Graphium type conidiation were also present. Considering these morphological characteristics, the isolate was suggested to be a member of the S. apiospermum species complex.
Macroscopic and microscopic morphology of the causative Scedosporium boydii. (A) A colony grown on potato dextrose agar is shown. (B) Microculture mount in lactophenol blue showing numerous annelloconidia (100×). (C) Close-up of the conidium and annellide showing rings (arrows) after conidiation is shown (40×, plus zoom 4).
The identity of Scedosporium boydii was finally achieved based on the sequencing of the PCR amplicon of the internal transcribed spacer 1 and internal transcribed spacer 2. The sequenced fragments matched 100% to S. boydii (formerly named Pseudallescheria boydii11). The accession numbers are JQ690940, AJ888398, AJ888383, AJ888394, and AJ888398.
DiscussionEndogenous endophthalmitis caused by the S. apiospermum species complex is not common and patients have typically a poor visual prognosis with a low likelihood of organ preservation. This disease has been diagnosed in patients with underlying systemic neutropenia, acute lymphocytic leukemia, Wegener's granulomatosis,8 organ transplant patients, and immunocompetent patients with pulmonary fibrosis.17
In the case described here, we think that uncontrolled diabetes mellitus was the main risk factor for the development of endophthalmitis, probably of endogenous origin. After a right femur surgery nine months prior to the ocular complaint, an unidentified infectious microorganism caused a transient blood infection with a septic embolus to the retina, which was the possible cause of the endogenous fungal endophthalmitis. The patient sought late for ophthalmic attention, which resulted in a delayed diagnosis. The fungus was present in the choroid and retina tissue smears, as well as in the cultures. Due to the retinal detachment, decreased ocular pressure, loss of light perception, the pain in the eye, and the risk of dissemination, enucleation was the better option.
In other cases, when an early diagnosis of this disease has been established, a therapeutic regimen consisting of vitrectomy with intravitreal 0.1% voriconazole and oral voriconazole at regular doses has been indicated with successful outcomes.19
In the present case, a very late diagnosis was established in a blind and painful eye; therefore, the patient was not treated with voriconazole. Enucleation was necessary for a complete removal of the infected tissues, preventing in this way a potential dissemination. The mycological and molecular studies confirmed S. boydii as the cause of the ocular mycosis.
S. apiospermum is a complex of species that reproduce asexually, although sexual reproduction, as in this case, is also possible.3 This holomorphic complex is genotypically diverse, and the techniques for identification and epidemiological studies are routinely used on pulmonary secretions obtained from cystic fibrosis patients.10
S. boydii is one of the most clinically relevant species in the S. apiospermum complex and is also the most virulent.6 Conventional phenotypic methods are of limited use for species differentiation within this complex, and precise identification requires molecular approaches.4,5 In the present case, the initial morphological identification was highly suggestive of a species of the S. apiospermum complex, but the molecular approaches were necessary to confirm the identity of the species. Endophthalmitis caused by species of the S. apiospermum complex is a devastating disease with a poor response to antifungal therapy and a poor visual outcome. To our knowledge, this is the first report of a S. boydii endophthalmitis in Mexico, which was confirmed by mycological molecular analyses.
Conflicts of interestAuthors declare that there are no conflicts of interest.
We thank QFB Erika Córdova-Martínez (Departamento de Microbiología y Parasitología, Facultad de Medicina, UNAM) for her technical support with the molecular procedures and Oscar Albis Donado, MD (ophthalmologist) for his assistance revising the manuscript.